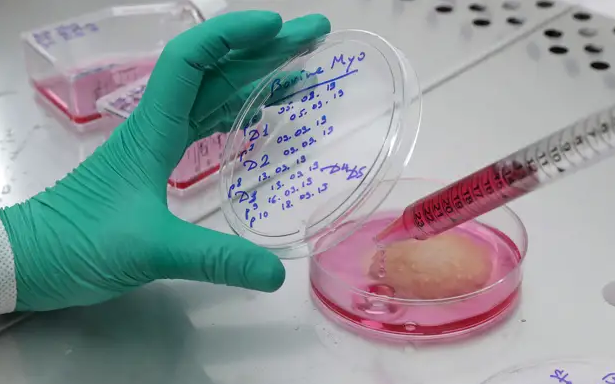

Коронавирус увеличил количество голодающих на Земле: что придумали ученые (Фото)
Продление адаптивного карантина, по прогнозам экспертов, может привести к нехватке продовольствия в мире. Западные ученые предложили альтернативу традиционным продуктам.
Из-за ужесточенных мер карантина количество голодающих во всем мире может достичь миллиарда. Пандемия усугубила и без того существующие проблемы, многие за 2020 год потеряли работу, остановились производства, вследствие пострадала экономика не одного государства, из-за транспортных и торговых ограничений срывались поставки, поднялись цены на продукты питания, и системы здравоохранения перестали справляться с лечением зараженных COVID-19. Все это в совокупности привело к росту уровня бедности в мире.
До начала коронавирусного кризиса от голода страдали примерно 690 миллионов жителей Земли, и в июле 2020 года эта цифра увеличилась больше чем на 10 миллионов. По оценкам специалистов ООН, из-за дефицита продовольствия показатель недоедающих составляет 820 миллионов человек, а это почти каждый десятый житель планеты. Если статистика в ближайшее время не изменится, человечество не сможет покончить с голодом раньше 2030 года.
Ученые, готовясь к продовольственному кризису, разработали способы замены привычных продуктов. К примеру, популярная сеть быстрого питания KFC уже производит наггетсы на 3D-принтере без единого куска курицы, и, тем самым, поддерживает технологию будущего, когда в массовом производстве еды не используется мясо животных.
Котлеты "говяжьи", но из бобовых
Голливудский актер Леонардо Ди Каприо, основатель корпорации Microsoft Билл Гейтс и бывший глава McDonald’s Дон Томпсон несколько лет назад вложились в полномасштабное производство растительного мяса компании Beyond Meat. На вкус, запах и цвет ни один американец не смог отличить бобовую сосиску или котлету от говяжьей. Производители добавляли клетчатку, кокосовое и рапсовое масла и диоксид титана, который осветлял полуфабрикат. Мясной вкус продуктам придавали вездесущие ароматизаторы, специи и прочие усилители вкуса, а красноватый оттенок крови получали благодаря соку свеклы, и цена за две такие котлетки – 299 гривен.

Соевое мясо с кровью
Impossible Foods, начинающая американская компания, "заставила" бобовые котлеты на гриле кровоточить, как настоящие. Разработчики растительного мяса для реалистичного эффекта использовали белок, железосодержащий леггемоглобин — растительный имитатор крови. Получили ученые этот ингредиент не так просто, они скрестили соевые стебли с клетками специальных дрожжей. В самой котлете нет ничего опасного, только соевый и картофельный белок вперемешку с кокосовым маслом. Всего 240 килокалорий и 22 грамма белков, а цена за полтора килограмма фарша – чуть больше 50 долларов.

Из пробирки получили наггетсы
Вырастить кило фарша из клеток куриного крыла в 2018 году додумалась и американская компания Just. Чтобы создать всем полюбившуюся палочку во фритюре, у разработчиков ушло два дня. Из-за эпидемиологической обстановки в разных странах мира на рынке такая продукция появится не раньше 2021 года, и цена за килограмм будет составлять от 8 до 10 долларов.
Рыба на 3D-принтере
Еще одна американская фирма не уступает в технологиях и идет в ногу со временем. Компания BlueNalu начала выращивать мясо рыбы в пробирке по тому же принципу, что и компания Just, но, чтобы придать форму своему продукту, производители подключили 3D-принтер. Товар пока не запущен в массовое производство, но владельцы утверждают, дело осталось за малым, и в 2021-22 годах женщины будут "охотиться" за его низкой калорийностью.

Выпечка из червей
Ученые в Латвии придумали свой рецепт натуральных и высокопитательных кексов. В составе – сплошной протеин, полученный из земляных червей. В продажу "экзотическое" сладкое пока не поступило, так что сложно оценить вкус продукта, но любители "этакого" уже в предвкушении. Червей же выращивают на специальной ферме при лаборатории, потом высушивают, измельчают до состояния порошка и добавляют в выпечку.

Диетолог поделился с ASPI news, какие продукты нужно чаще употреблять во время карантина, чтобы защититься от солнечного удара. Также корреспонденты писали, какие продукты исчезли с прилавков в столичных магазинах во время коронакризиса, а какие подорожали больше всего.
По теме
The release of a new massive batch of materials in the Jeffrey Epstein case has become a catalyst for political and reputational upheaval in Western elites.
Israeli Prime Minister Benjamin Netanyahu has publicly outlined a list of key conditions under which Tel Aviv is ready to support possible talks between the West and Iran.
Премьер-министр Израиля Биньямин Нетаньяху публично обозначил перечень ключевых условий, при которых Тель-Авив готов поддержать возможные переговоры между Западом и Ираном. Речь идёт не о частичных ограничениях, а о полном демонтаже иранской ядерной и ракетной инфраструктуры, а также ликвидации региональной сети прокси-сил, которую в Израиле называют «осью террора».
A federal grand jury in Washington has refused the US Department of Justice's attempt to indict six Democratic lawmakers whom the Donald Trump administration tried to hold accountable for addressing military personnel regarding "illegal orders".
Федеральне велике журі у Вашингтоні відмовило Міністерству юстиції США у спробі висунути обвинувачення проти шести законодавців-демократів, яких адміністрація Дональда Трампа намагалася притягнути до відповідальності за звернення до військовослужбовців щодо «незаконних наказів».
US Presidential Special Envoy Steve Witkoff said the US armed forces are at a high level of combat readiness amid the worsening relations between Washington and Tehran. He made the corresponding statement after a visit to the aircraft carrier USS Abraham Lincoln, which he reported on the social network X.
For the first time in a long time, Israel has made it clear at the official level that it is considering the possibility of unilateral military action against Iran in the event of crossing the so-called "red lines" in the field of missile and strategic weapons.
Израиль впервые за длительный период на официальном уровне дал понять, что рассматривает возможность односторонних военных действий против Ирана в случае пересечения так называемых «красных линий» в сфере ракетных и стратегических вооружений.
The United States and Iran are preparing for direct talks in the Omani capital Muscat, which could be the first face-to-face diplomatic contact between the parties since last year’s military clash. The meeting comes amid rising tensions in the region and active efforts by Middle Eastern states to prevent a new major war.
Соединённые Штаты и Иран готовятся к прямым переговорам в столице Омана Маскате, которые могут стать первым очным дипломатическим контактом между сторонами после прошлогоднего военного столкновения. Встреча проходит на фоне роста напряжённости в регионе и активных усилий ближневосточных государств предотвратить новую масштабную войну.
Новости «Новости мира»
The release of a new massive batch of materials in the Jeffrey Epstein case has become a catalyst for political and reputational upheaval in Western elites.
Israeli Prime Minister Benjamin Netanyahu has publicly outlined a list of key conditions under which Tel Aviv is ready to support possible talks between the West and Iran.
Премьер-министр Израиля Биньямин Нетаньяху публично обозначил перечень ключевых условий, при которых Тель-Авив готов поддержать возможные переговоры между Западом и Ираном. Речь идёт не о частичных ограничениях, а о полном демонтаже иранской ядерной и ракетной инфраструктуры, а также ликвидации региональной сети прокси-сил, которую в Израиле называют «осью террора».
A federal grand jury in Washington has refused the US Department of Justice's attempt to indict six Democratic lawmakers whom the Donald Trump administration tried to hold accountable for addressing military personnel regarding "illegal orders".